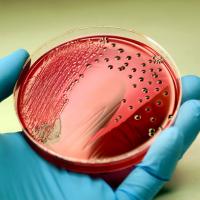

- Salute
Articolo
Il GILS, Gruppo Italiano per la Lotta alla Sclerodermia, con i suoi volontari, rilancia, anche quest’anno, il suo appuntamento istituzionale “La Giornata del Ciclamino”, da giovedì 26 a domenica 29 settembre 2019.
Da giovedì a domenica 100 piazze italiane si coloreranno con i ciclamini per informare, far conoscere la sclerodermia, una patologia... Continua
Articolo
Oltre cinquecento esperti si sono riuniti a Padova, in occasione del convegno “Ipovitaminosi D: sindrome o malattia? Diverse forme, diversi fattori di rischio” presieduto dal professor Carlo Foresta, per discutere del frequente riscontro di ridotti livelli di vitamina D in Italia.
L’80% della popolazione italiana è carente di vitamina D e sono... Continua
Articolo
La sclerosi multipla è una malattia neurologica progressiva caratterizzata da infiammazione cronica del tessuto cerebrale e da lesioni alla guaina mielinica che avvolge i prolungamenti nervosi garantendone l’integrità e consentendo la trasmissione veloce dei segnali. È opinione comune che la microglia, le cellule immunitarie del sistema nervoso,... Continua
Articolo
Una rapida e non invasiva scansione degli occhi può identificare mutamenti nella retina che aiutano a diagnosticare il morbo di Alzheimer.
È il risultato di una nuova ricerca di studiosi del Centre for Eye Research Australia (CERA) e dell'Università di Melbourne, che hanno usato una tecnologia specializzata di scansione per identificare la prima... Continua
Articolo
Anche brevi periodi di interruzione dell'attività fisica hanno un effetto negativo sulla salute. Da qui l'importanza di mantenersi fisicamente attivi in modo continuativo.
È quanto emerge da uno studio delle Università di Newcastle e Liverpool, in Gran Bretagna, presentato al 55° Congresso dell'Associazione Europea per lo Studio del Diabete (EASD... Continua
Articolo
Disponibile negli ospedali italiani una nuova cura contro l'emicrania. La malattia colpisce di più le donne e in Italia le persone che ne soffrono in maniera cronica sono circa nove milioni, con ricadute pesanti sul lavoro dove fa registrare il 14% di assenze totali.
Ad annunciare questa vera e propria rivoluzione nelle cure è il responsabile del... Continua
Articolo
Il colesterolo basso è un nuovo fattore di rischio per la salute mentale. È associato, infatti, a un incremento della probabilità di tentare il suicidio, poiché può far “saltare” un freno all'aggressività e all'impulsività.
Lo dimostra una ricerca presentata al Convegno Internazionale di Suicidologia e Salute Pubblica, tenutosi nei giorni scorsi a... Continua
Articolo
ENEA, in collaborazione con Istituto Nazionale Tumori Regina Elena e Istituto Dermatologico San Gallicano di Roma, ha realizzato un prototipo che permetterà di misurare in tempo reale e in modo più accurato l’effettiva dose di radiazioni rilasciata e assorbita dal paziente durante il trattamento oncologico.
Il progetto RI.GUI.DO - RIlascio a GUIda... Continua
Articolo
Ecco perché col passare degli anni si fa più fatica a dimagrire: le cellule della “massa grassa” (tessuto adiposo), gli adipociti, diventano più “lente”, o in altri termini il ricambio del grasso (ciclo di rimozione e accumulo di grasso al loro interno) diviene via via meno rapido, indipendentemente da altri fattori quali l'alimentazione.
Lo... Continua
Articolo
Se fosse una malattia sarebbe la seconda più letale al mondo, con 7-9 milioni di morti l'anno, molti di più rispetto ad esempio ai 7-800.000 dell'HIV-AIDS.
Quella legata alla sepsi, hanno ricordato lo scorso 13 settembre gli esperti in occasione del World Sepsis Day, giornata mondiale che sensibilizza su questa condizione, è una crisi globale di... Continua
Categoria
autore
- redazione (1127) Apply redazione filter
- Andrea Cuscona (20) Apply Andrea Cuscona filter
- Julia Karpova (9) Apply Julia Karpova filter
- Federica Campilongo (8) Apply Federica Campilongo filter
- Sarah Donzuso (7) Apply Sarah Donzuso filter
- Antonio Percolla (6) Apply Antonio Percolla filter
- Sabrina Portale (6) Apply Sabrina Portale filter
- Marisa Falcone (5) Apply Marisa Falcone filter
- Anna Arietti (4) Apply Anna Arietti filter
- Davide Di Paola (4) Apply Davide Di Paola filter
- Santo Gulisano (4) Apply Santo Gulisano filter
- Benedetto Rizzo (3) Apply Benedetto Rizzo filter
- Guido Bissanti (3) Apply Guido Bissanti filter
- Jose Marano (3) Apply Jose Marano filter
- Steven Giuffrida (3) Apply Steven Giuffrida filter
- Tiziano Fusella (3) Apply Tiziano Fusella filter
- Angela Longo (2) Apply Angela Longo filter
- Caterina Lenti (2) Apply Caterina Lenti filter
- Claudia Signorelli (2) Apply Claudia Signorelli filter
- Cristian Fioriglio (2) Apply Cristian Fioriglio filter
- Federica Catalano (2) Apply Federica Catalano filter
- Francesca Romana Golino (2) Apply Francesca Romana Golino filter
- Francesca Santangelo (2) Apply Francesca Santangelo filter
- Gaetano Lo Monaco e Angela Longo (2) Apply Gaetano Lo Monaco e Angela Longo filter
- Maria Rita Ursino (2) Apply Maria Rita Ursino filter
- Raffaella Sacco (2) Apply Raffaella Sacco filter
- Salvina Favara (2) Apply Salvina Favara filter
- Adriana Alberghina (1) Apply Adriana Alberghina filter
- Barbara Corbellini (1) Apply Barbara Corbellini filter
- Mimmo Scollo (1) Apply Mimmo Scollo filter
- Paolo Reitano (1) Apply Paolo Reitano filter
- Riccardo Anastasi (1) Apply Riccardo Anastasi filter
- Rosa Rita Bellia (1) Apply Rosa Rita Bellia filter
- Valerio Gullotta (1) Apply Valerio Gullotta filter
- Vittoria Averni (1) Apply Vittoria Averni filter